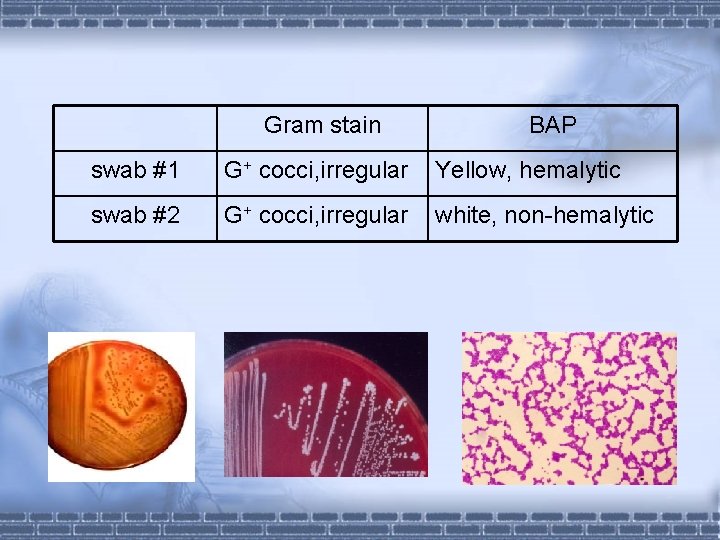
Gram stain BAP swab #1 G+ cocci, irregular Yellow, hemalytic swab #2 G+ cocci, Gram stain BAP swab #1 G+ cocci, irregular Yellow, hemalytic swab #2 G+ cocci,

Experiment 6 Isolation identification of pathogenic cocci The

- Slides: 9
Experiment 6 Isolation & identification of pathogenic cocci
The common procedures of the Isolation & Identification of pathogenic cocci Smears (Gram-stain) Specimens Isolation culture Morphological characteristics (Microscopic examination) colonial morphology observation Colonial characteristics Hemolytic reaction Pigmentation (blood agar plate) stained and observe typical colonies Direct identification Pure culture Antibiotic susceptibility test
Materials • Specimen: Pus swab (#1 and #2), and throat swab • Culture : blood agar plate (BAP) • Equipments: alcohol lamp, inoculating loop, slide, marking pencil • Reagent: gram stain reagent: Crystal violet Iodine solution Alcohol 95% Safranin solution
Procedures test 1:Isolation culture § Inoculate the swabs to blood agar by four-area streak technique separately. • Incubate them overnight at 37℃. test 2:Smears § Make Gram stain of swabs, and examine them under oil-immension objective.
Four-area streak dilution technique area 1 rolled with pus swab area 2 -4 streaked with inoculating loop 1/10 1/5 1/4
Gram stain § Prepare a smear § Pass the slide over flame § Stain Crystal violet for 1 min, then wash Iodine for 1 min, then wash 95% alcohol for 15 sec, then wash Safranin for 1 min, then wash § Dry with bibulous paper § Observe it under oil-immension objective § Record the results.
Procedures Smears (Gram-stain) Specimens Isolation culture Morphological characteristics (Microscopic examination) colonial morphology observation Colonial characteristics Hemolytic reaction Pigmentation (blood agar plate) stained and observe typical colonies Direct identification Pure culture Antibiotic susceptibility test
Gram stain BAP swab #1 G+ cocci, irregular Yellow, hemalytic swab #2 G+ cocci, irregular white, non-hemalytic
Coagulase Test Procedures 1) Divide the slide into two equal parts 2) place two loops of NS on the left side and on the right side respectively 3) Emulsify the colonies in them respectively 4) Gently shake the slide and observe the result 5) Repeat the above steps for another bacterium’s colonies